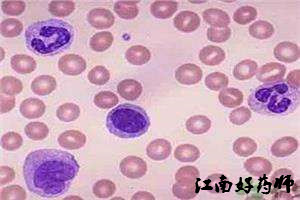
必看超全的临床常用化验单解读,手把手教你看懂医院化验单

今天小编讲一些常用的医学检查指标,讲的简单些,实用些
第一类 血常规检查
一、红细胞计数(RBC)
【正常参考区间】
成人
男:(4.0-5.5) ×10¹² /L
女:(3.5-5.0) ×10¹² /L
二、血红蛋白(Hb)
血红蛋白常被称为“血色素”,是组成红细胞的主要成分。
【正常参考区间】
女性:110-150g/L
男性:120-160g/L
新生儿:170~200g/L

红细胞计数(RBC)及血红蛋白(Hb)的临床意义
解读1:红细胞/血红蛋白增多
①相对增多:
频繁呕吐、出汗过多,大面积烧伤等,由于大量失水使血浆减少,血液浓缩,血中各种有形成分包括红细胞相对增多,仅为一种暂时的现象。
②代偿性和继发性增多:
常继发于慢性肺心病、肺气肿、高原病和肿瘤患者,可引起红细胞代偿性增生;
③真性红细胞增多:
为原因不明的慢性骨髓功能亢进,红细胞计数可达(7.0-12.0) ×1012 /L。
解读2:红细胞/血红蛋白减少
①急性、慢性红细胞丢失过多:常由各种原因的出血引起,如消化道溃疡、痔疮、十二指肠钩虫病等。
②红细胞生成减少:
如:再生障碍性贫血;如骨髓病性贫血;巨幼细胞性贫血;慢性病贫血;肾性贫血。
血红蛋白生成减少:
如:缺铁性贫血、铁粒幼细胞性贫血、铅中毒贫血、珠蛋白合成障碍性贫血。
③红细胞破坏过多
解读3.血红蛋白(Hb)/红细胞数量(RBC)与贫血
贫血——即RBC及Hb减少。血红蛋白(Hb)比红细胞数量(RBC)能更好地反映贫血的程度。
贫血按严重程度可分为:
轻度贫血,Hb量在>90 g/L;
中度贫血,Hb量在>61~90g/L;
重度贫血,Hb量在31~60g/L;
极重度贫血,Hb量<30g/L;
三、白细胞计数(WBC)
【正常参考区间】
成人静脉血:(3.5~10.0)×109/L(略不同于末梢血)
新生儿:(15.0~20.0)×10 9/L(显著高于成人)
【正常参考区间】——白细胞有以下分类
中性分叶核粒细胞(中性粒细胞)0.50~0.70(50%-70%)
中性杆状核粒细胞0.01~0.06(1%~6%)
嗜酸性粒细胞 0.01~0.05(1%~5%);
儿童0.005~0.05(0.5%~5%)
嗜碱性粒细胞0~0.01(0%~1%)
淋巴细胞0.20~0.40(20%~40%)
单核细胞0.03~0.08(3%~8%)
由于中性粒细胞在白细胞所占百分率高(50%~70%),因此它的数值增减是影响白细胞总数的关键。
解读1:中性粒细胞增加(只谈病理性)
急性感染和化脓性炎症、中毒、急性大出血、白血病、骨髓增殖性疾病及恶性肿瘤、严重的组织损伤及大量红细胞破坏(严重外伤、大手术、大面积烧伤)
解读2:中性粒细胞减少
主要一些特殊感染
如革兰阴性菌感染(伤寒、副伤寒)、结核分枝杆菌感染、病毒感染(风疹、肝炎、感冒)、 寄生虫感染(疟疾)
解读3:嗜酸性粒细胞增多
①过敏、寄生虫
②药物:应用头孢拉定、头孢氨苄、头孢呋辛、头孢哌酮等抗生素等
③血液病:慢性粒细胞性白血病、嗜酸性粒细胞性白血病等。
解读4:嗜酸性粒细胞减少
伤寒、副伤寒、大创伤;长期用肾上腺皮质激素
解读5:淋巴细胞增多
①百日咳、传染性单核细胞增多症、传染性淋巴细胞增多症、结核病、水痘、麻疹、风疹、流行性腮腺炎、传染性肝炎、结核及许多传染病的恢复期。
②血液病(白血病)
③肾移植术后发生排斥反应时。
解读6: 淋巴细胞减少
多见于传染病的急性期、放射病、细胞免疫缺陷病(如艾滋病)、长期应用肾上腺皮质激素后或接触放射线等。
解读7: 单核细胞增多可见于: 结核、伤寒、亚急性细菌性心内膜炎
四、血小板计数(PLT)——血小板是由骨髓巨核细胞产生的
【正常参考区间】
(100~300)× 10^9/L
解读: 血小板减少
(1)血小板生成减少——造血功能损伤(再障、白血病)
(2)血小板破坏过多——免疫性或继发性血小板减少性紫癜/脾亢/体外循环
(3)血小板消耗过多——如弥漫性血管内凝血
(4)血小板分布异常——脾肿大
(5)药物中毒或过敏引起——磺胺药
第二类 尿常规检查
1、尿蛋白(PRO)阳性:肾损害
2、尿隐血(BLD)阳性:
尿血红蛋白阳性:红细胞被大量破坏
尿血红蛋白阳性:红细胞被大量破坏
3、尿葡萄糖(GLU)阳性:
阳性+血糖正常:提示肾脏损害
阳性+血糖↑:提示可能有糖尿病
4、尿胆红素(BIL)阳性:提示可能肝细胞或胆道阻塞性黄疸
第三类 粪常规检查
1、稀糊状或水样粪便——感染或非感染性腹泻、急性胃肠炎
2、脓血便——细菌性痢疾(以脓为主)、阿米巴痢疾(以血为主)
3、米泔水样便——霍乱、副霍乱
4、鲜血便——下消化道出血
5、柏油便——上消化道出血
6、白陶土便——阻塞性黄疸
第四类 肝功能检查

一、血清丙氨酸氨基转移酶(ALT)、 血清天门冬氨酸氨基转移酶(AST)
①正常值参考范围均为<40U/L
②主要存在于心肌、肝、肾、骨骼肌、胰腺等,指标升高,反应这些部位的损伤,尤其是肝胆疾病损伤。
③在急性或轻型肝炎时,血清ALT升高幅度大于AST ;在慢性肝炎尤其是肝硬化时,AST上升的幅度高于ALT。AST/ALT比值越高,肝脏病变越慢性化。
④使用肝毒*药性**物可使二者均升高:抗生素、抗真菌药、抗病毒药、他汀类调血脂药
二、血清总蛋白(TP)、白蛋白(A)和球蛋白(G)
①白蛋白——属于非急性时相蛋白。
维持渗透压和营养状况,减少反应肝功能受损。营养不良、消耗过多、丢失过多、合成障碍(肝)均可使之降低。
②球蛋白——急性时相蛋白。
参与机体免疫,增高见于炎症、感染、自身免疫病、骨髓瘤、淋巴瘤;降低见于长期应用肾上腺皮质激素和免疫*制剂抑**。
③A/G比值小于1(白蛋白少):提示有慢性肝炎、肝硬化、肝实质性损害、肾病综合征。
三、胆红素
1.胆红素的来源
(1)大部分胆红素:衰老红细胞(80%~85%)。
(2)小部分胆红素:来自组织(特别是肝细胞)。
(3)极小部分胆红素:骨髓内无效造血的血红蛋白。
2.根据总胆红素(STB)值判定有无黄疸
STB升高 + 非结合胆红素(旧称间接胆红素)升高 = 溶血性黄疸
STB升高 + 结合胆红素(旧称直接胆红素)明显升高 = 胆汁淤积性黄疸
三者均升高 = 提示肝细胞性黄疸。
第五类 肾功能检查

一、血清尿素氮(BUN)
当此值高于正常时,说明有效肾单位的60%~70%已受损害。因此尿素氮测定不能作为肾病早期肾功能不全的测定指标,但对肾衰竭,尤其是氮质血症的诊断有特殊的价值。
二、血肌酐(Cr)
当肾实质受到损害时,肾小球的滤过率就会降低,血肌酐浓度就会上升。
血肌酐增高见于:各种类型肾病,导致肾小球滤过功能下降
第六类 乙型肝炎血凊免疫学检查
检查项目(两对半)大小临床意义
1.乙型肝炎病毒表面抗原(HBsAg):为乙型肝炎病毒 (HBV)表面的一种糖蛋白,表明体内有病毒存在。
2.乙型肝炎病毒表面抗体(HBsAb):人体针对乙型肝炎病毒表面抗原产生的中和抗体,为一种保护性抗体,表明人体具有一定的免疫力。
3.乙型肝炎病毒e抗原(HBeAg):位于HBV病毒颗粒的核心部分,其阳性是乙肝病毒复制、增殖、有传染性的指标之一。
4.乙型肝炎病毒e抗体(HBeAb): 是e抗原的对应抗体,非中和抗体(没有保护作用),不能抑制HBV的增殖,是反映肝细胞受到HBV侵害后的一项指标。
5.乙型肝炎病毒核心抗体(HBcAb):非保护性抗体,不能抑制HBV的增殖,反映肝细胞受到HBV侵害的一项指标.

▲大三阳和小三阳的临床意义
1、“大三阳”(感染病毒,并高度活跃、复制)
①表面抗原、e抗原、核心抗体同为阳性——上面1/3/5阳性
②乙肝病毒在人体内复制活跃,带有传染性,应尽快隔离。
2、“小三阳”(感染病毒,复制力减少)
①表面抗原、e抗体、核心抗体同为阳性——上面1/4/5阳性!
②乙肝病毒人体内复制减少,传染性小,不需要隔离;如肝功能正常,又无症状,成为乙型肝炎病毒无症状携带者。